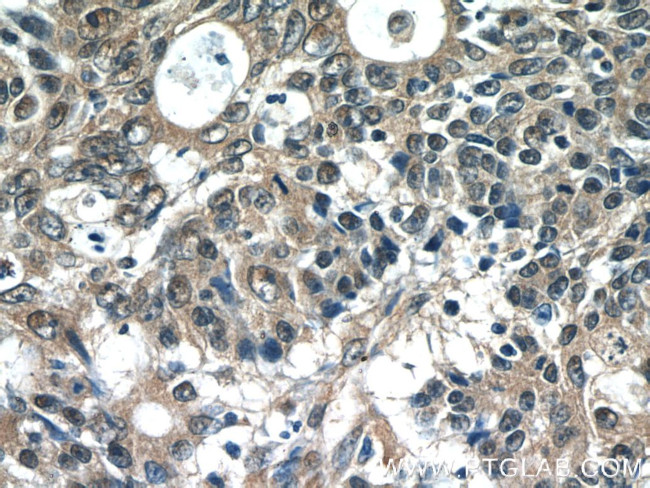
SCFD2 Antibody in Immunohistochemistry (Paraffin) (IHC (P))

Search
Proteintech
SCFD2 Polyclonal Antibody
{{$productOrderCtrl.translations['antibody.pdp.commerceCard.promotion.promotions']}}
{{$productOrderCtrl.translations['antibody.pdp.commerceCard.promotion.viewpromo']}}
{{$productOrderCtrl.translations['antibody.pdp.commerceCard.promotion.promocode']}}: {{promo.promoCode}} {{promo.promoTitle}} {{promo.promoDescription}}. {{$productOrderCtrl.translations['antibody.pdp.commerceCard.promotion.learnmore']}}








Please note: We are reviewing Western blot images included in the antibody testing data in our catalog, including those provided by third parties. Unless expressly labeled or annotated as “raw-unedited”, Western blot images included in the antibody testing data in our catalog may have been edited, optimized or otherwise adjusted for presentation.
产品信息
13375-1-AP
种属反应
宿主/亚型
分类
类型
抗原
偶联物
形式
浓度
规格
纯化类型
保存液
内含物
保存条件
运输条件
产品详细信息
Immunogen sequence: MSASGVLSF TQQGWEQVLA KVKRAVVYLD AACAESLHWG CGSTRLLEAV GGPDCHLREF EPDAIGGGAK QPKAVFVLSC LLKGRTVEIL RDIICRSHFQ YCVVVTTVSH AVHLTANHVP AAAAAEMEGQ QPVFEQLEEK LCEWMGNMNY TAEVFHVPLL LAPVAPHFAL TPAFASLFPL LPQDVHLLNS ARPDKRKLGS LGDVDSTTLT PELLLQIRCL VSGLSSLCEH LGVREECFAV GSLSQVIAAD LANYAPAKNR KKTAAGRASV VFVDRTLDLT GAVGHHGDNL VEKIISALPQ LPGHTNDVMV NMIALTALHT EEENYNVVAP GCLSQSSDTT AKALWEALLN TK (1-351 aa encoded by BC032453)
靶标信息
SCFD2 may be involved in protein transport.
仅用于科研。不用于诊断过程。未经明确授权不得转售。
篇参考文献 (0)
生物信息学
蛋白别名: Neuronal Sec1; Sec1 family domain-containing protein 2; Syntaxin-binding protein 1-like 1
基因别名: E430013M20Rik; Scfd2; STXBP1L1
UniProt ID: (Mouse) Q8BTY8
Entrez Gene ID: (Mouse) 212986, (Rat) 498353